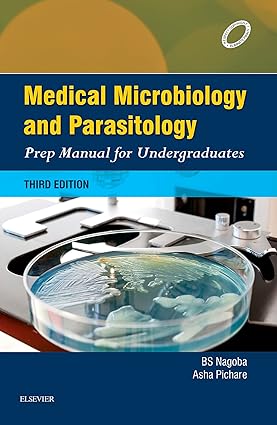
Microbiology and Parasitology PMFU 3rd Edition

Medical Science Books
Showing 2161–2200 of 3699 results
-

Medical Surgical Nursing By Kochuthresiamma Thomas
6,950.75 PKR Add to cart -

Medical Surgical Nursing Concepts & Practice 5th Edition
29,193.15 PKR Add to cart -

Medical Surgical Nursing Made Incredibly Easy
12,789.38 PKR Add to cart -

Medical Surgical Nursing Volume1 Preparatory Manual for Undergraduates
2,502.27 PKR Add to cart -

Medical Terminology & Anatomy for Coding 3rd Edition
25,578.76 PKR Add to cart -

Medical Terminology A Short Course 9th Edition
16,403.77 PKR Add to cart -

Medical Terminology Documentation and Coding
23,632.55 PKR Add to cart -

Medications and Mothers Milk 17th Edition
17,793.92 PKR Add to cart -

Medicine Management Skills for Nurses 2nd Edition
9,174.99 PKR Add to cart -

Medicines Ethics and Practice 43rd Edition
19,740.13 PKR Add to cart -

Medicolegal Reporting in Orthopaedic Trauma 4th Edition
80,072.64 PKR Add to cart -

Medtech Pocket Medical
834.09 PKR Add to cart -

Membrane Receptors Channels and Transporters in Pulmonary Circulation
41,704.50 PKR Add to cart -

Mental Toughness The Mindset Behind Sporting Achievement 2nd Edition
13,901.50 PKR Add to cart -

Mercers Textbook of Orthopaedics and Trauma 10th Edition
74,512.04 PKR Add to cart -

Merenstein & Gardners Handbook of Neonatal Intensive Care An Interprofessional Approach
32,251.48 PKR Add to cart -

Meriams Engineering Mechanics Statics SI Version 9th Edition
18,906.04 PKR Add to cart -

Merrills Atlas of Radiographic Positioning and Procedures 3 Volume Set 13th Edition
83,687.03 PKR Add to cart -

Merritts Neurology 14th Edition
57,552.21 PKR Add to cart -

Mesenteric Principles of Gastrointestinal Surgery Basic and Applied Science
47,543.13 PKR Add to cart -

Metabolic Engineering for Bioactive Compounds Strategies and Processes
53,103.73 PKR Add to cart -

Metal Allergy From Dermatitis to Implant and Device Failure
44,484.80 PKR Add to cart -

Metallic Biomaterials New Directions and Technologies
60,332.51 PKR Add to cart -

Metals and Life
9,731.05 PKR Add to cart -

Metastasis of Colorectal Cancer
56,162.06 PKR Add to cart -

Methods of Economic Research Craftsmanship and Credibility in Applied Microeconomics
23,632.55 PKR Add to cart -

Michlovitzs Modalities for Therapeutic Intervention
31,139.36 PKR Add to cart -

Microalgal Hydrogen Production Achievements and Perspectives
76,458.25 PKR Add to cart -

Microbiology A Systems Approach 6th Edition
18,628.01 PKR Add to cart -

Microbiology An Introduction 12th Edition
6,116.66 PKR Add to cart -
Microbiology and Parasitology PMFU 3rd Edition
3,892.42 PKR Add to cart -

Microbiology for the Healthcare Professional 3rd Edition
32,529.51 PKR Add to cart -

Microbiology Manual
834.09 PKR Add to cart -

Microinjection Methods and Protocols
49,489.34 PKR Add to cart -

MicroRNA in Human Malignancies
54,771.91 PKR Add to cart -

Middletons Allergy 2 Volume Set Principles and Practice 8th Edition
97,032.47 PKR Add to cart -

Miller & Freunds Probability And Statistics For Engineers 8th Edition
1,946.21 PKR Add to cart -

Millers Anesthesia 2 Volume Set 9th Edition
102,871.10 PKR Add to cart -

Millers Basics of Anesthesia 8th Edition
31,417.39 PKR Add to cart -

Millers Review of Orthopaedics 8th Edition
4,170.45 PKR Add to cart